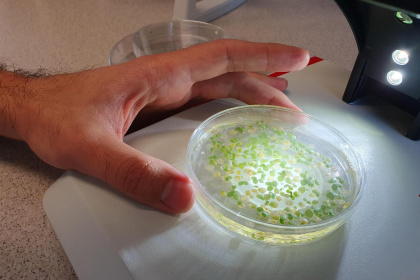

HomeAbout usSASTA BlogMay 2024
About us
May 2024
Tips & Tricks for a Winning Project
Posted by Oliphant Science Awards
on 30/05/2024

Check out below some advice for putting together your winning Oliphant's project! Have you seen our NEW project checklists? Make sure you've ticked off all the essential elements of your project, from putting it together all the way through to submitting it. Find them on each category page or in...
Space Agriculture: From Crater to Plate
Posted by SASTA
on 27/05/2024
With the Aurora Australis visible in the last couple of weeks you have probably spent some time staring up at the stars. Maybe wondering about the next Moon mission, or what life on Mars could look like? Space is an ever-fascinating topic, and a subject that truly brings science as...
Science Active School - Annesley Junior School
Posted by SASTA
on 20/05/2024

Years awarded: 2024 & 2025 Science at Annesley Junior School Annesley Junior School has been thrilled to be recognised as a Science Active School in 2024. At Annesley science is celebrated and passions are developed. The specialist science teacher sees all classes in the school and has a dedicated science...
A Day in the Life of the Adelaide Planetarium
Posted by SASTA
on 15/05/2024

Over 400 years ago Johannes Kepler gazed into the night sky and revolutionised our understanding by revealing that planets orbit in ellipses rather than perfect circles, with those nearer to the sun moving at a faster pace than their distant counterparts. Today, within the Planetarium’s immersive dome, participants embark on...
Science Active School - Kangaroo Island Community Education
Posted by SASTA
on 06/05/2024

Years awarded: 2023, 2024 & 2025 What Makes Kangaroo Island Community Education a Science Active School? SASTA Corporate member Participate in the Oliphant Science Awards Staff have participated in judging for OSA Staff member has been a member of the OSA Committee since 2020 Staff have regularly attended SASTA conferences...
In this Section
Archive
- June 2026
- May 2026
- April 2026
- March 2026
- February 2026
- January 2026
- December 2025
- November 2025
- October 2025
- September 2025
- August 2025
- July 2025
- June 2025
- May 2025
- April 2025
- March 2025
- February 2025
- January 2025
- December 2024
- November 2024
- October 2024
- September 2024
- August 2024
- July 2024
- June 2024
- May 2024
- April 2024
- March 2024
- February 2024
- December 2023
- November 2023
- October 2023
- September 2023
- July 2023
- June 2023
- May 2023
- April 2023
- March 2023
- February 2023
- January 2023
- December 2022
- November 2022
- October 2022
- August 2022
- July 2022
- June 2022
- May 2022
- April 2022
- March 2022
- February 2022
- January 2022
- December 2021
- November 2021
- October 2021
- September 2021
- August 2021
- July 2021
- June 2021
- May 2021
- April 2021
- March 2021
- February 2021
- January 2021
- December 2020
- November 2020
- October 2020
- September 2020
- August 2020
- July 2020
- June 2020
- May 2020
- April 2020
- October 2018
- September 2018
- August 2018
- July 2018
